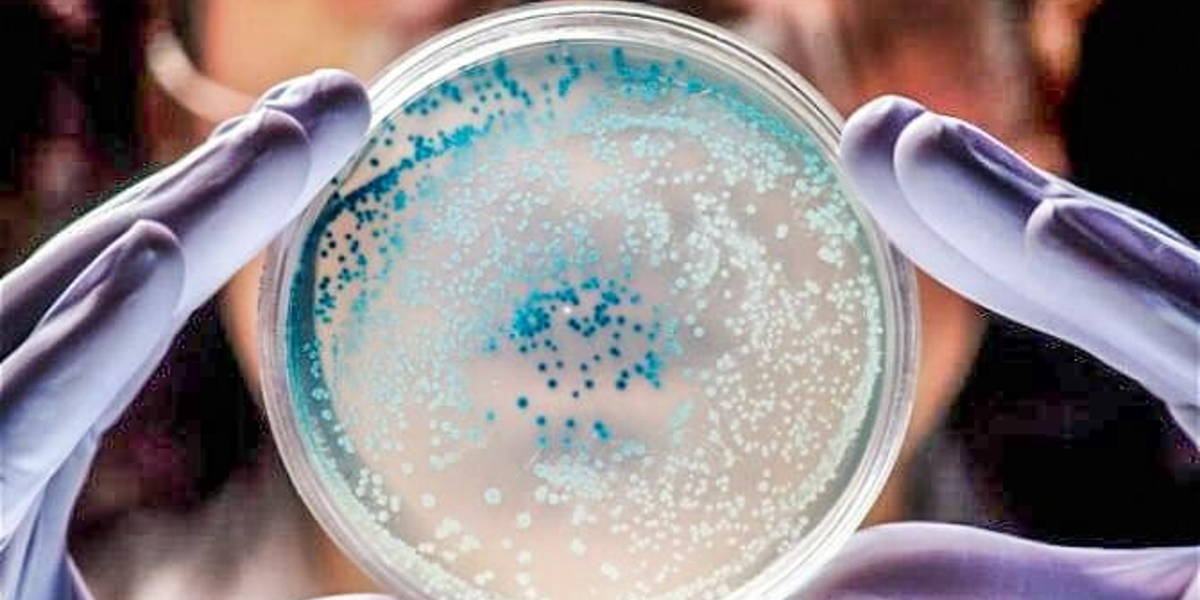

This robot searches for deadly bacteria and identifies them. Then they can be destroyed using a bacteriophage. “A bacteriophage, a Greek word for eater of bacteria, is the bacteria’s natural enemy en can be found in nature in even greater numbers than bacteria”, so says Joris Krijger, director of the TROIKA Foundation. “bacteriophages are everywhere and break down bacteria all over the world.
With the invention of antibiotics the phages have been forgotten in the west. Right now, in Israel, Georgia and Poland there are still institutes who work with bacteriophages. With the decrease of the effectiveness of antibiotics, the interest in bacteriophages increased in the West. In the US, Switserland and The Netherlands companies are engaged in Phage therapy.”
“The major problem with phages is that they must be deployed very precisely in order to be effective”, Krijger continues. “This means they will have to be matched exactly with the bacteria they have to destroy. For a long time this was a problem, but the Troika Foundation saw an opportunity to overcome this limitation using new detection techniques.”
Search, Identify & Destroy
The result is a SID robot (See, Identify, Destroy). This robot will be developed within the Dutch Medical Delta: The Med/Tech consortium of the University of Leiden, The TU Delft and the Erasmus University in Rotterdam. “The robot has a flexible housing. This means it can operate in a static housing (a hanging system above an assembly line in a foodplant) and in a mobile housing (a robot scanning and decontaminating in an Operating Room). For this system we are not bound by one type of robot, which increases our chances in actually getting a working robot.”
“When an ‘early-warning’ is given, an indication of the presence of unwanted bacteria, we’ll start ‘identifying’ using a DNA-sequencing technique. This technique tells us precisely what the bacteria’s genetic makeup is. With this information a fitting phage will be found in the phage database and administered. The phage works directed and only kills the harmful bacteria. After this fase one will be run again to make sure the unwanted bacteria have been eliminated. We’ve patented this technique and we’ll further develop it the coming years.”
“Unfortunately, it will take a couple of years before the robot can start. First a ‘proof of concept’ has to be made. Besides that a large databank has to be made, with information on as many bacteria there is to find. “If all goes according to plans we hope the present the first prototype within three years, so before the end of 2018. When there’s more public support and funding, this could be greatly accelerated."
With the right contacts, doors will open
Krijgers plan is ambitious and hinges on good partners. The Troika Foundation is not a large pharmaceutical firm, but a small foundation. But with the right contacts, doors will open. “Our ambassador Ard Struijs (internist at Erasmus MC) give us access to the Erasmus University for clinical trials. “Generade is our partner in the development of the identification stage. This company is located on the Leidse BioSciencepark and collaborates with the LUMC, the University of Leiden and the Leiden Academy. At the moment we’re also talking with the TU Delft. The TU Twente also showed interest in the development of our robot, but depending on the talks in Delft, the robot will be developed in the Medical Delta."
If the development of the robot succeeds, it doesn’t end there. Bacteria keep on evolving. “The promises to detect and destroy all multi resistant bacteria is therefore not realistic. What is possible, and we think is the most important, is to trace and kill the most harmful multi-resistant bacteria. Therefore, we begin with the multi-resistant bacteria that make the most victims at this time, like the MRSA. After that, we’ll teach the robot to recognise and destroy bacteria on its own, so that in time the robot can track and destroy the vast majority of the multi-resistant bacteria."